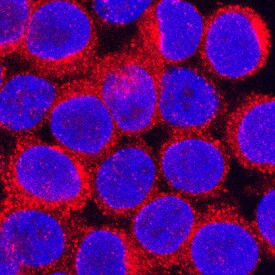
CCL3 Antibody in Immunocytochemistry (ICC/IF)

Search
Invitrogen
CCL3 Polyclonal Antibody
{{$productOrderCtrl.translations['antibody.pdp.commerceCard.promotion.promotions']}}
{{$productOrderCtrl.translations['antibody.pdp.commerceCard.promotion.viewpromo']}}
{{$productOrderCtrl.translations['antibody.pdp.commerceCard.promotion.promocode']}}: {{promo.promoCode}} {{promo.promoTitle}} {{promo.promoDescription}}. {{$productOrderCtrl.translations['antibody.pdp.commerceCard.promotion.learnmore']}}
图: 1 / 6
CCL3 Antibody (PA5-46951) in ICC/IF






Please note: We are reviewing Western blot images included in the antibody testing data in our catalog, including those provided by third parties. Unless expressly labeled or annotated as “raw-unedited”, Western blot images included in the antibody testing data in our catalog may have been edited, optimized or otherwise adjusted for presentation.
产品信息
PA5-46951
种属反应
已发表种属
宿主/亚型
分类
类型
抗原
偶联物
形式
浓度
规格
纯化类型
保存液
内含物
保存条件
运输条件
RRID
产品详细信息
In sandwich ELISAs, less than 0.03% cross-reactivity with recombinant human (rh) CCL3, recombinant mouse (rm) CCL9/10, and rmCCL4 and less than 0.4% cross-reactivity with rhCCL7.
Reconstitute at 0.2 mg/mL in sterile PBS.
Endoxin level is <0.10 EU per 1 µg of the antibody by the LAL method.
靶标信息
Both MIP-1alpha and MIP-1beta are structurally and functionally related CC chemokines. They participate in host response to invading bacterial, viral, parasite and fungal pathogens by regulating the trafficking and activation state of selected subgroups of inflammatory cells (e.g. macrophages, lymphocytes and NK cells). While both MIP-1alpha and MIP-1beta exert similar effects on monocytes, their effect on lymphocytes differ; with MIP-1alpha selectively attracting CD8+ lymphocytes, and MIP-1beta selectively attracting CD4+ lymphocytes. Additionally, MIP-1alpha and MIP-1beta have also been shown to be potent chemoattractants for B cells, eosinophils and dendritic cells. Both human and murine MIP-1alpha and MIP-1beta are active on human and murine hematopoietic cells.
仅用于科研。不用于诊断过程。未经明确授权不得转售。
生物信息学
蛋白别名: C-C motif chemokine 3; H-MIP-1-alpha; Heparin-binding chemotaxis protein; L2G25B; LD78-alpha; Macrophage inflammatory protein 1-alpha; macrophage inflammatory protein-1alpha; MIP-1 alpha; MIP-1-alpha; MIP1 (a); mip1 alpha; RP23-320E6.7; SIS-alpha; small inducible cytokine A3; Small-inducible cytokine A3; TY-5
基因别名: AI323804; Ccl3; G0S19-1; LD78alpha; MIP-1alpha; MIP1-(a); MIP1-alpha; Mip1a; Scya3
UniProt ID: (Mouse) P10855
Entrez Gene ID: (Mouse) 20302